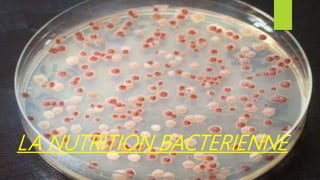
LA NUTRITION BACTERIENNE
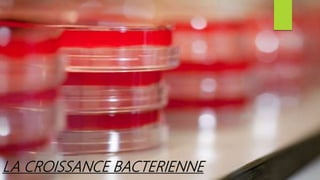
LA CROISSANCE BACTERIENNE
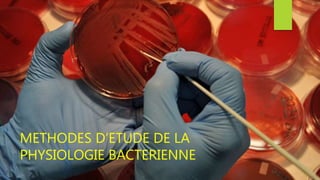
METHODES D’ETUDE DE LA
PHYSIOLOGIE BACTERIENNE

Ce document présente un cours de biologie infectieuse axé sur la physiologie bactérienne, détaillant la nutrition, la croissance et les méthodes d'étude des bactéries. Il aborde les besoins nutritifs essentiels, les conditions de croissance optimales et les différentes techniques utilisées en microbiologie pour le diagnostic et l'identification bactérienne. Les applications de ces connaissances incluent la médecine, l'industrie et le contrôle de la stérilisation.